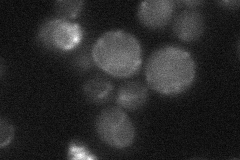
YGR096W
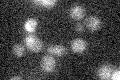
YGR096W

View description
Mitochondrial membrane transporter that mediates uptake of the essential cofactor thiamine pyrophosphate (ThPP) into mitochondria; expression appears to be regulated by carbon source; member of the mitochondrial carrier family
Localization:
Intensity:
Fold change:
Significance:
-
C’ GFP library in SD

below threshold14.91 -
N' NOP1pr-GFP in SD

mitochondria42.5282 -
N' TEF2pr-mCherry in SD

mitochondria0 -
N' NATIVEpr-GFP in SD
below threshold20.5716 -
N' TEF2pr-VC and Cyto-VN in SD

#N/A0 -
C’ GFP library in SD+DTT

cytosol13.270.88No -
C’ GFP library in SD+H2O2

cytosol13.590.91No -
C’ GFP library in Starvation Media
cytosol13.940.93No -
C’ GFP library on the background of Pup2-DaMP

below threshold -
C’ GFP library on the background of CCT mutant

below threshold16.33321.09479No
